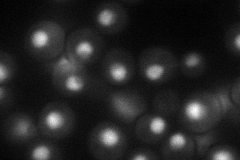
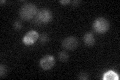

View description
Cleavage and polyadenylation factor I (CF I) component involved in cleavage and polyadenylation of mRNA 3' ends; bridges interaction between Rna15p and Hrp1p in the CF I complex
Localization:
Intensity:
Fold change:
Significance:
-
C’ GFP library in SD

below threshold16.55 -
N' NOP1pr-GFP in SD
nucleus,nucleolus55.4588 -
N' TEF2pr-mCherry in SD

nucleus,nucleolus25.7761 -
N' NATIVEpr-GFP in SD

nucleus45.411 -
N' TEF2pr-VC and Cyto-VN in SD

#N/A0 -
C’ GFP library in SD+DTT

cytosolN/AN/ANo -
C’ GFP library in SD+H2O2

cytosolN/AN/ANo -
C’ GFP library in Starvation Media
cytosolN/AN/AYes -
C’ GFP library on the background of Pup2-DaMP

below threshold -
C’ GFP library on the background of CCT mutant

below thresholdN/AN/ANo
